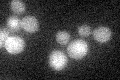
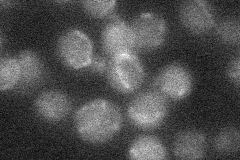
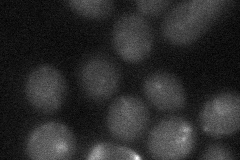

View description
TLC1 RNA-associated factor involved in telomere length regulation as the recruitment subunit of the telomerase holoenzyme, has a possible role in activating Est2p-TLC1-RNA bound to the telomere
Localization:
Intensity:
Fold change:
Significance:
-
C’ GFP library in SD
below threshold17.79 -
N' NOP1pr-GFP in SD

nucleolus35.7615 -
N' TEF2pr-mCherry in SD

nucleus,nucleolus12.6902 -
N' NATIVEpr-GFP in SD
punctate19.0056 -
N' TEF2pr-VC and Cyto-VN in SD
below threshold24.0989 -
C’ GFP library in SD+DTT

cytosol18.661.04No -
C’ GFP library in SD+H2O2

cytosol18.411.03No -
C’ GFP library in Starvation Media

cytosol15.620.87No -
C’ GFP library on the background of Pup2-DaMP

below threshold -
C’ GFP library on the background of CCT mutant

below threshold17.58720.988498No
